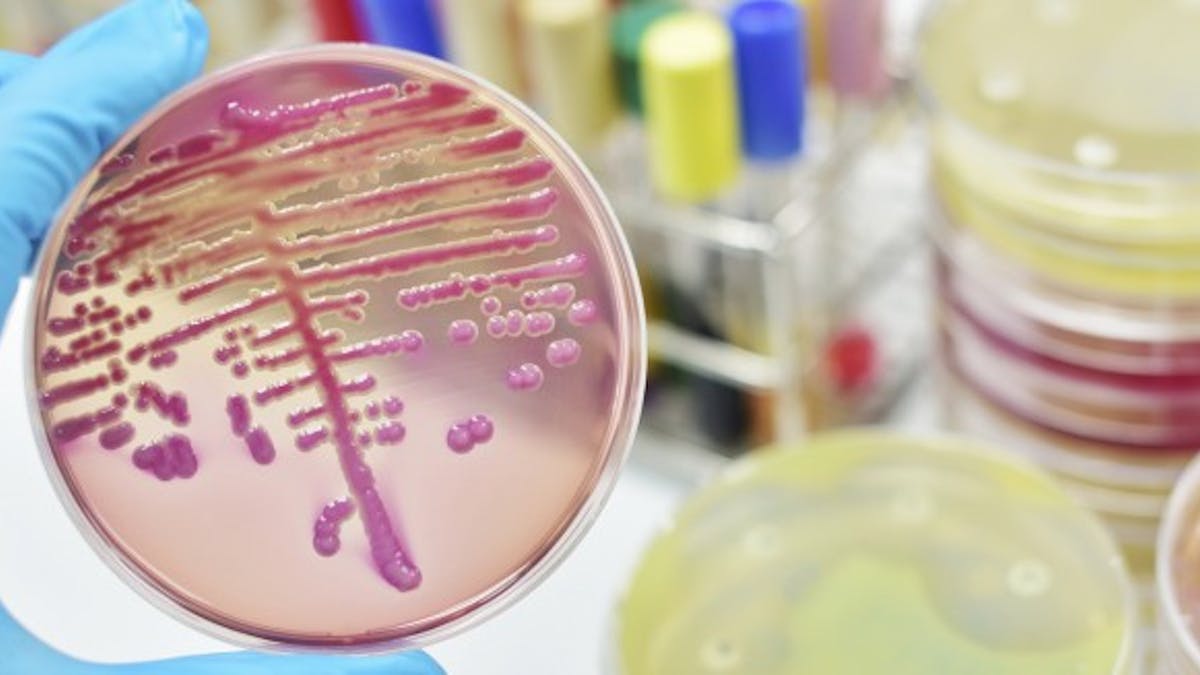

septicémie chance de survie
La probabilité de vivre au moins cinq ans après le diagnostic sappelle le taux de survie à cinq ans. Lessymptômes de la septicémie ne sont pas.

Le Sepsis Une Personne En Meurt Toutes Les 3 4 Secondes Dans Le Monde Sciences Et Avenir
Cest beaucoup mieux quil y a seulement quarante ans où la survie globale nétait que de 3.
. Symptôme de septicémie. Au cours de la digestion après un brossage des dents. La septicémie se traduit par une infection généralisée responsable dune fièvre élevée mais parfois au contraire dune chute de la température du corps. La septicémie peut survenir pendant que vous êtes encore à lhôpital à la fin dune intervention mais ce nest pas toujours le cas.
Il est important de consulter immédiatement un médecin si vous présentez lun des symptômes ci-dessous. En effet il sagit dune réaction inflammatoire de notre corps face à une forte infection quelle quelle soit. Décharges brèves de bactéries dans le sang qui peuvent être observées dans les circonstances suivantes. La septicémie ou bactériémie associée à un sepsis est une infection qui sest généralisée dans tout le corps en passant par le sang.
Si vous présentez des symptômes de septicémie ou de septicémie après une chirurgie ou une infection assurez-vous de consulter immédiatement un médecin. En labsence de traitement et de surveillance médicale appropriés les chances de survie sont médiocres. Ce taux pour la leucémie est quatre fois plus élevé quil ne létait dans les années 1960. Un électrocardiogramme pour évaluer le fonctionnement du cœur.
Le pronostic de la septicémie est souvent assez sombre. Hier hospitlaisée durgence il lui a été diagnostiqué une septicémie. Cette infection sous-jacente peut donc avoir diverses origines et caractéristiquesLa septicémie urinaire quant à elle indique que le dérèglement se trouve dans les voies urinaires du patient. Ma mére âgée de 66ans a subi une pose de valve cardiaque il y a 4ans opération trés réussie.
Le taux de survie global à 5 ans pour le cancer du foie tous cas confondus est de 18. Cest le résultat surprenant dune étude qui sest essentiellement penchée sur les. Les patients atteints dun cancer du foie de stade 1 localisé ont un taux de survie à. 25-40 des patients décèdent en dépit de lantibiothérapie et des soins de médecine durgence le plus souvent parce que la septicémie a été diagnostiquée trop tardivement.
Une septicémie urinaire est un grave trouble de la santé. Présence de bactérie dans le sang prouvé par les hémocultures Septicémie terme qui nest plus utilisé 1 Bactériémie asymptomatique et transitoire. Symptômes de la septicémie. Plus le nombre de patients traités au service des Urgences est élevé plus le taux de survie est bon.
La réactualisation de ces recommandations est spécifiée dans le tableau 1. Le terme de septicémie. Les principales causes sont les médicaments de chimiothérapie le cancer les traumatismes graves les brûlures le diabète insuffisance rénale ou hépatique le soutien ventilateur et le cathétérisme invasif. Selon une étude publiée dans Critical Care Medicine le taux de mortalité hospitalière due à une septicémie grave est passé de 47 entre 1991 et 1995 à 29 entre 2006 et 2009.
Aujourdhui le taux moyen de survie à cinq ans pour tous les types de leucémie est de 658. Par contre elle a contractée une maladie nosocomiale suite à cette op qui se caractérise par des ulcéres sur les 2jambes. Les patients atteints de la défense défectueuse sont à risque élevé de développer une septicémie et une défaillance multiviscérale. La septicémie frapperait plus dun million dAméricains et 15 à 30 dentre eux en meurt selon les autorités sanitaires américainesUn décès sur cinq dans le monde est associé à la septicémie selon une étude publiée dans la revue médicale The LancetMalgré cela près de la moitié de la population na jamais entendu parler de.
Le diagnostic rapide de la septicémie chez les patients hospitalisés est crucial car dans les cas graves il y a une diminution moyenne de 76 du taux de survie par heure sans traitement. Hémodynamique du sepsis sévère et organisée conjointement par la Société de réanimation de langue française SRLF et la Société française danesthésie-réanimation SFAR. Plus tôt vous vous faites soigner plus. En France la mortalité des patients atteints dun sepsis est en moyenne de 27 mais plusieurs paramètres peuvent influencer la mortalité.
Peut on se sortir dune septicémie.

Septicemie Definition Symptomes Traitement Qu Est Ce Que Le Sepsis

Septicemie Definition Symptomes Traitement Qu Est Ce Que Le Sepsis

La Septicemie Une Infection Grave Femme Actuelle Le Mag

La Septicemie Une Infection Grave Femme Actuelle Le Mag

3 Choses A Savoir Sur Le Sepsis Septicemie Sante Magazine

Sante L 39 Aspirine Efficace Contre La Septicemie Tribune De Geneve
Posting Komentar untuk "septicémie chance de survie"